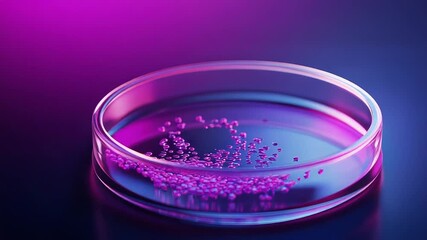
Petri dish with pink substance under neon light, scientific experiment - Powered by Adobe

- Home >Â
- Stock Videos >Â
- Digital Representation of DNA and Virus Cells in Pink Background
Digital Representation of DNA and Virus Cells in Pink Background Video
Digital rendering showcasing intertwined DNA helixes with stylized virus cells on a pink backdrop. Designed to highlight scientific concepts, both COVID-19 and general genetics. Useful for educational material, research presentations, and science communications, offering a visually striking representation of molecular biology. Ideal for engaging audiences interested in human biology and viral studies.
Â
downloads
downloads
Tags:
More
Credit Photo
If you would like to credit the Photo, here are some ways you can do so
Text Link
video Link
<span class="text-link">
<span>
<a target="_blank" href=https://pikwizard.com/video/digital-representation-of-dna-and-virus-cells-in-pink-background/52c845396693220a575a523edcdb3337/>PikWizard</a>
</span>
</span>
<span class="image-link">
<span
style="margin: 0 0 20px 0; display: inline-block; vertical-align: middle; width: 100%;"
>
<a
target="_blank"
href="https://pikwizard.com/video/digital-representation-of-dna-and-virus-cells-in-pink-background/52c845396693220a575a523edcdb3337/"
style="text-decoration: none; font-size: 10px; margin: 0;"
>
<video controls style="width: 100%; margin: 0;">
<source src="https://player.vimeo.com/progressive_redirect/playback/736613121/rendition/240p/file.mp4?loc=external&oauth2_token_id=1223210874&signature=ff57ed51c0e2a0810a678eb479775e1b31ae2a9e2f16ebd60c1c3cedcd33a775" type="video/mp4"
poster="https://pikwizard.com/pw/medium/52c845396693220a575a523edcdb3337.jpg"/>
Your browser does not support the video tag.
</video>
<p style="font-size: 12px; margin: 0;">PikWizard</p>
</a>
</span>
</span>
Free (free of charge)
Free for personal and commercial use.
Author: Awesome Content
Similar Free Stock Videos
Loading...